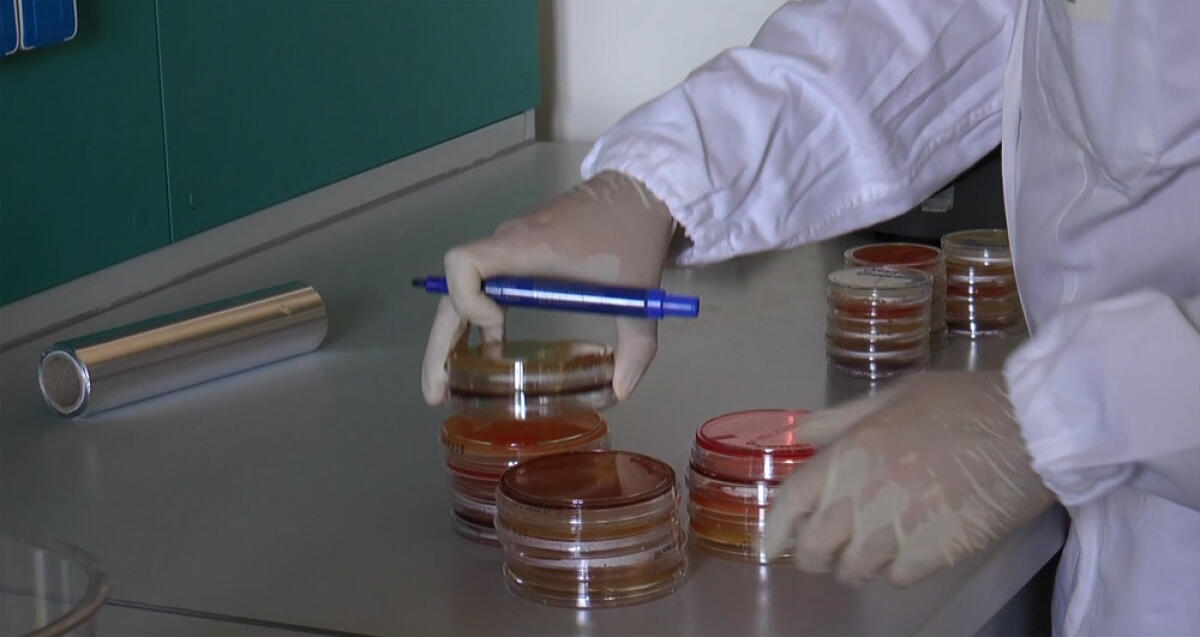
Vaccino anti-Covid: già disponibili nelle Asl del Lazio 32 tank congelatori. A Latina arrivati i primi due. -

Vaccino anti-Covid: già disponibili nelle Asl del Lazio 32 tank congelatori. A Latina arrivati i primi due.
Vaccino anti-Covid: la Regione Lazio dispone già di 32 tank congelatori pronti nelle Asl e nelle Aziende ospedaliere e nelle strutture accreditate, compresi i Policlinici universitari e gli Istituti d...
A cura di
Redazione
19 dicembre 2020 12:56
Vaccino anti-Covid: la Regione Lazio dispone già di 32 tank congelatori pronti nelle Asl e nelle Aziende ospedaliere e nelle strutture accreditate, compresi i Policlinici universitari e gli Istituti di Ricovero e Cura a Carattere Scientifico.
“Di questi – fa sapere la Regione - 15 sono congelatori da 800 litri di capienza e 17 congelatori da 400 litri, per un totale di stoccaggio di circa 1 milione di dosi. All’ospedale Goretti di Latina, nelle scorse ore, sono arrivati i primi due congelatori.
 18.2°
18.2°



